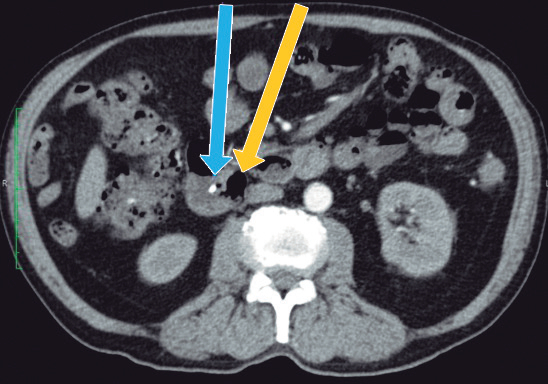

Casos clínicos

Esta obra está bajo una Licencia Creative Commons Atribución-NoComercial-CompartirIgual 4.0 Internacional.
Recepción: 22 Enero 2022
Aprobación: 19 Marzo 2022
Publicación: 30 Marzo 2022
DOI: https://doi.org/10.52787/agl.v52i1.170
Resumen: El síndrome de Lemmel es una entidad infrecuente, que causa obstrucción biliar debido a la compresión del conducto colédoco por un divertículo duodenal periampular. Puede manifestarse como un cuadro de colangitis aguda y, a menudo, suele ser infradiagnosticado. Sin embargo, un vez identificado, puede ser tratado exitosamente, siendo la colangiopancreatografía retrógrada endoscópica uno de los métodos más utilizados. El síndrome de Lemmel debe ser considerado en pacientes ancianos, con diagnóstico de divertículo duodenal periampular, una vez que se haya descartado la presencia de coledocolitiasis y neoplasias pancreatobiliares.
Palabras clave: Obstrucción biliar, divertículo periampular, colangitis aguda.
Abstract: Lemmel syndrome is a rare entity that causes biliary obstruction due to compression of the common bile duct by a periampullary diverticulum. It can manifest as acute cholangitis and is often underdiagnosed. However, once identified, it can be successfully treated with endoscopic retrograde cholangiopancreatography, being one of the most used methods. Lemmel syndrome should be considered in elderly patients with a diagnosis of periampullary duodenal diverticulum, once the presence of choledocholithiasis and pancreatobiliary neoplasms have been ruled out.
Keywords: Biliary obstruction, periampullary diverticulum, acute cholangitis.
Introducción
El síndrome de Lemmel es una entidad infrecuente, que se manifiesta como un cuadro de ictericia obstructiva causada por la compresión de la porción intrapancreática del conducto biliar común, debido a un divertículo duodenal periampular (DDP). Esto condiciona la dilatación de los conductos biliares extra e intrahepáticos por encima de este. Este síndrome se presenta en ausencia de coledocolitiasis y neoplasias pancreatobiliares.1 El DDP está compuesto por herniaciones de la mucosa duodenal, que carecen de una capa muscular y están ubicadas en un radio de 2 a 3 cm de la ampolla de Vater.2 La mayoría de los pacientes con DDP son asintomáticos y, por lo general, se descubre mediante estudios endoscópicos o de imágenes (por ejemplo: tomografía abdominal computarizada y colangiopancreatografía por resonancia magnética [CPRM]). En raras ocasiones, los DDP pueden causar complicaciones (pancreatobiliares y no pancreatobiliares). Las complicaciones pancreatobiliares a veces se manifiestan como un cuadro de ictericia obstructiva, condicionando el desarrollo del síndrome de Lemmel.3,4,5 El síndrome de Lemmel es considerado una causa infrecuente de colangitis aguda y, dado que son pocos los casos reportados, hasta la fecha no existe un consenso sobre su manejo definitivo.
A continuación, presentamos un caso de colangitis aguda, secundaria a síndrome de Lemmel, tratado exitosamente mediante colangiopancreatografía retrógrada endoscópica (CPRE) más esfinterotomía biliar.
Caso clínico
Paciente varón de 82 años, admitido en el servicio de emergencias del hospital, con un tiempo de enfermedad de dos semanas de evolución, caracterizado por dolor abdominal en el cuadrante superior derecho (CSD), fiebre e ictericia en escleras. En la exploración física se destacó la presencia de ictericia en escleras y la presencia de dolor a la palpación en CSD, con signo de Murphy negativo. Los análisis de laboratorio mostraron: recuento de leucocitos 18.7x109/L con 8% de abastonados, proteína C reactiva (PCR) 6,54 mg/dl, bilirrubina total 4,74mg/dl (bilirrubina directa 2,48mg/dl), TGO 382 U/L, TGP 377 U/L, fosfatasa alcalina 167 U/L, gamma-glutamil-transpeptidasa 1044 U/L y albúmina 2,7g/dl. La CPRM reveló una dilatación del conducto biliar común y del conducto pancreático principal a nivel de la cabeza del páncreas, sin evidencia de lesiones, y un divertículo de 23 x 21 mm a nivel de la segunda porción duodenal. No se observó dilatación de la vía biliar intrahepática ni evidencia de litos en la vía biliar o en la vesícula biliar (Figura 1).

Figura 1
Colangiopancreatografía por resonancia magnética, que muestra un divertículo duodenal periampular (flecha roja) y dilatación del conducto biliar común (flecha azul).
Con los hallazgos mencionados, se realizó el diagnóstico de colangitis grado II (sobre la base de los criterios diagnósticos y de severidad de las guías de Tokyo),6 y se inició tratamiento antibiótico. Posterior a las primeras 24 horas del diagnóstico, el paciente fue sometido a CPRE, en la que se identificaron tres divertículos duodenales periampulares. Debido a que la canulación fue difícil, tuvo que realizarse, durante el procedimiento, la técnica de rendez-vous (guiada por ecografía y fluoroscopía), utilizando el acceso transparietohepático para lograr el ingreso a la vía biliar. En la colangiografía, el conducto biliar se encontraba dilatado (10 mm) y no se evidenciaron imágenes por defecto de relleno. Se realizó una esfinterotomía mínima y se colocó una prótesis biliar plástica de 10 Fr x 7 cm para poder asegurar un adecuado drenaje de la vía biliar. El paciente evolucionó favorablemente. Al momento del alta no presentaba dolor abdominal, había normalizado los valores de leucocitos y PCR, y los valores de colestasis se encontraban en descenso. En los controles posteriores, el paciente presentó dolor abdominal esporádico en el CSD, pero el examen físico y los análisis de sangre no mostraron mayores alteraciones. El paciente contaba, además, con una tomografía abdominal con contraste, que no aportó información adicional a la evidenciada en la CPRM (Figuras 2 y 3).

Figura 2
Tomografía abdominal (corte coronal): divertículo duodenal periampular (flecha roja) y prótesis biliar plástica en el conducto biliar común (flecha amarilla).
Figura 3
Tomografía abdominal (corte axial): divertículo duodenal periampular (flecha amarilla) y prótesis biliar plástica en el conducto biliar común (flecha celeste).
Por la edad del paciente, el hallazgo de los DDP y la dilatación del conducto pancreático principal, se decidió complementar el estudio diagnóstico con la realización de una ultrasonografía endoscópica (USE) biliopancreática, para descartar la presencia de neoplasias pancreatobiliares no evidenciadas en los estudios previos de imágenes. La USE biliopancreática mostró la presencia de un DDP de gran tamaño, dilatación coledociana y escaso barro en la vesícula biliar. El páncreas no presentaba alteraciones y el conducto pancreático principal no se encontraba dilatado. Con los hallazgos descritos, se descartó la presencia de coledocolitiasis y neoplasias pancreatobiliares, y se postuló como hipótesis diagnóstica el síndrome de Lemmel. El tratamiento elegido fue la realización de CPRE más esfinterotomía biliar, dada su baja tasa de morbimortalidad y la alta probabilidad de éxito, sobre la base de los reportes de casos previos. El paciente fue sometido a una nueva CPRE, en la cual se retiró la prótesis biliar (Figuras 4 y 5). La colangiografía mostró dilatación del colédoco (Figura 6), sin evidencia de litiasis. Se realizó el pasaje del balón extractor de vía biliar sin evidenciarse salida de litos ni barro biliar al retirarse este. Posteriormente, se amplió el acceso a la vía biliar mediante esfinterotomía, siendo adecuados el drenaje de bilis y el contraste. El hallazgo de barro en la vesícula biliar fue resuelto mediante colecistectomía laparoscópica. El paciente fue dado de alta sin molestias y el control de la analítica sanguínea fue normal. Tras seis meses de seguimiento, el paciente aún permanece asintomático.

Figura 4
Hallazgos endoscópicos durante la CPRE: divertículo duodenal periampular y prótesis biliar plástica.

Figura 5
Hallazgos endoscópicos durante la CPRE: divertículo duodenal periampular.

Figura 6
Colangiografía que muestra dilatación del conducto biliar común, sin evidencia de imágenes, por defecto del relleno.
Discusión
Aproximadamente el 5% de los casos de pacientes con DDP pueden presentar complicaciones (pancreatobiliares y no pancreatobiliares).7,8 Las complicaciones pancreatobiliares pueden manifestarse como ictericia obstructiva, colangitis aguda o pancreatitis aguda.7,8 Los mecanismos postulados en la patogénesis del síndrome de Lemmel incluyen: a) irritación mecánica directa del DDP, que provoca inflamación crónica de la ampolla de Vater y que conduce a fibrosis, b) disfunción del esfínter de Oddi, c) compresión mecánica del colédoco o de la ampolla de Vater por el DDP, lo que aumenta la presión en el conducto biliar o en el conducto pancreático.1,4,9 Los estudios por imágenes nos permiten detectar la presencia de los DDP y excluir otras etiologías. Las pruebas de elección son: tomografía computada abdominal, CPRM, CPRE y USE, siendo las dos últimas las de mayor utilidad.10 Tanto la tomografía abdominal como la CPRM pueden revelar herniaciones de la pared delgada, que surgen de la pared medial del duodeno (divertículos). En determinadas situaciones, estos divertículos pueden llenarse de líquido y diagnosticarse erróneamente como un absceso pancreático, una neoplasia quística en la cabeza pancreática o un ganglio linfático metastásico.11 Debido a que, en nuestro paciente, en la CPRM se evidenció una dilatación del conducto de Wirsung, decidimos complementar el estudio diagnóstico con una USE para descartar la presencia de neoplasias pancreatobiliares. La dilatación del conducto biliar y del conducto pancreático en el síndrome de Lemmel puede ser explicada teniendo en cuenta los mecanismos relacionados con su patogénesis (compresión mecánica del colédoco o de la ampolla de Vater por el DDP). El tratamiento del síndrome de Lemmel está determinado por la presencia o ausencia de síntomas y su patogenia.12 La conducta expectante está indicada en los pacientes asintomáticos. En los pacientes con manifestaciones clínicas relacionadas con la obstrucción biliar, está indicado el tratamiento quirúrgico (diverticulectomía o anastomosis biliodigestiva) o endoscópico (extracción endoscópica del material atrapado en el DDP, esfinterotomía endoscópica o litotricia extracorpórea por ondas de choque).3,7,9,13,14 La esfinterotomía biliar es más útil ante la sospecha de papilitis fibrosa crónica o disfunción del esfínter de Oddi.2 En nuestro caso, la colangitis aguda debida al síndrome de Lemmel fue resuelta mediante la realización de CPRE más esfinterotomía. Luego del tratamiento, el paciente fue monitorizado de forma ambulatoria y, hasta el momento, tras seis meses de seguimiento, continúa asintomático.
En conclusión, en todos los pacientes con obstrucción biliar y presencia de un DDP en los que los estudios por imágenes descarten la presencia de coledocolitiasis o neoplasias pancreatobiliares, el síndrome de Lemmel debe ser considerado dentro de los diagnósticos diferenciales, y la CPRE debe considerarse el tratamiento de elección en la mayoría de los casos.
Referencias
1. Desai K, Wermers J, Beteselassie N. Lemmel syndrome secondary to duodenal diverticulitis: A case report. Cureus. 2017;9(3):e1066.
2. Takakura, K, Koido, S, Kajihara, M, et al. Repetitive acute cholangitis and pancreatitis due to Lemmel syndrome: A case report. Int. J Diagnostic Imaging. 2014;1(2):88-91.
3. Tobin R, Barry N, Foley NM, et al. A giant duodenal diverticulum causing Lemmel syndrome. J Surg Case Rep. 2018;2018(10):1-3.
4. Wen-Jun Z, Zheng-Ming Z, Hong-Liang L. Submucosal Juxtapapillary Duodenal Diverticulum Complicated with Lemmel's Syndrome: A Case Report and Literature Review. J Clin Case Rep. 2020;10(3):1-4.
5. Sugimoto H, Fujikawa A, Kishida A. A rare complication of the duodenal diverticulum. Frontline Gastroenterol. 2020;11(1):81-2.
6. Miura F, Okamoto K, Takada T, et al. Tokyo Guidelines 2018: initial management of acute biliary infection and flowchart for acute cholangitis. J Hepatobiliary Pancreat Sci. 2018;25:31-40.
7. Kang HS, Hyun JJ, Kim SY, et al. Lemmel's syndrome, an unusual cause of abdominal pain and jaundice by impacted intradiverticular enterolith: case report. J Korean Med Sci. 2014;29(6):874-8.
8. Figueroa-Rivera I, Class-Vazquez W, Martin J. Lemmelʼs syndrome: a rare phenomenon causing obstructive jaundice. Am J Gastroenterol. 2017;112:722-3.
9. Rouet J, Gaujoux S, Ronot M, et al. Lemmel's syndrome as a rare cause of obstructive jaundice. Clin Res Hepatol Gastroenterol. 2012;36(6):628-31.
10. Rodríguez R, Polanía H, Evers G. A Case of Lemmel's Syndrome: A Rare Cause of Non-Neoplastic Obstruction of the Biliary Tract. Rev Colomb Gastroenterol. 2017;32(1):60-4.
11. Macari M, Lazarus D, Israel G, et al. A: Duodenal diverticula mimicking cystic neoplasms of the pancreas: CT and MR imaging findings in seven patients. AJR Am J Roentgenol. 2003;180(1):195-9.
12. Bernshteyn M, Rao S, Sharma A, et al. Lemmel's Syndrome: Usual Presentation of an Unusual Diagnosis. Cureus. 2020;12(4):e7698.
13. Nonaka T, Inamori M, Kessoku T, et al. Acute obstructive cholangitis caused by an enterolith in a duodenal diverticulum. Endoscopy. 2010;42:E204-E205.
14. Yoneyama F, Miyata K, Ohta H, et al. Excision of a juxtapapillary duodenal diverticulum causing biliary obstruction: report of three cases. J Hepatobiliary Pancreat Surg. 2004;11(1):69-72.
Abreviaturas
DDP: Divertículo duodenal periampular
CPRM: Colangiopancreatografía por resonancia magnética
CPRE: Colangiopancreatografía retrógrada endoscópica
USE: Ultrasonografía endoscópica
CSD: Cuadrante superior derecho
Notas
Notas de autor
Correspondencia: Julio Francisco León Moreno Correo electrónico: juliolm58@hotmail.com
